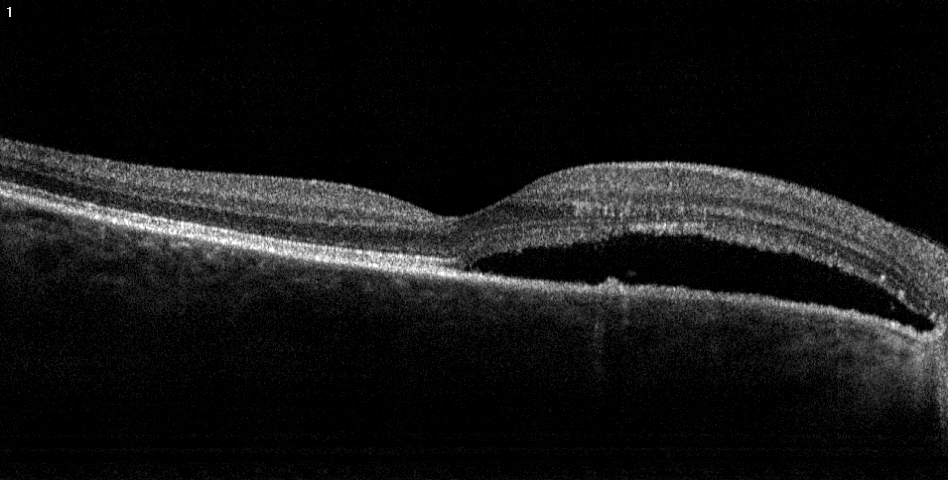

Central serous chorioretinopathy (CSCR)
Central serous chorioretinopathy (CSCR, sometimes CSR) is a disease that usually affects middle-aged patients. Men have a higher rate of affliction.
The hallmark of this disease is the development of fluid under the retina, in the so-called subretinal space. Various metabolic processes lead to an increase of pressure and subsequently, to the development of a small hole in the lowest layer of the retina, the pigment epithelium. As a result, fluid then enters the subretinal space. Common complaints are grey spots in the center of vision and sometimes lines that are bent or curved instead of being straight.
Generally, the disease is benign. The fluid disappears by itself in the months thereafter without any specific treatment. Rarely, however, the fluid does not dissipate or there are frequent recurrences. This can lead to an irrevocable loss of vision, because the sensory cells of the retina lose their functional capability. As a result, a treatment may be necessary.
The most important risk factor for the disease is stress. Many patients who have the disease describe physical, emotional or psychological stress. Furthermore, cortisone in any form, i.e. as a lotion or injection or as an oral medication, is also a risk factor. As a result, patients with CSCR are usually advised to avoid cortisone in any form other that in vital situations.
The current treatment options are:
- Stress reduction, watchful waiting: as the disease is most often benign, the reduction of stress, the avoidance or cessation of cortisone use and careful observation are often sufficient.
- Photodynamic therapy (PDT): In this treatment, the patient receives an IV with a specific, photosensitive drug. The eye is then irradiated with a weak laser beam to activate the drug that subsequently treats the underlying hyperactive areas of the retina/choroid. This treatment is very effective, but the effect is not immediate, i.e. the patient notices an improvement only after a couple of weeks.
-
Oral medication: there are certain oral medications which reduce the body’s own (endogenous) cortisone production and are thus used in this disease. They are generally not quite as effective as PDT, but can be an option for certain patients.
-
Laser: In certain, cases, a laser may be used to seal the leaking area of the retina. Laser therapy can rarely lead to the irreversible formation of blind spots, however, so it is only used in certain, select cases.

